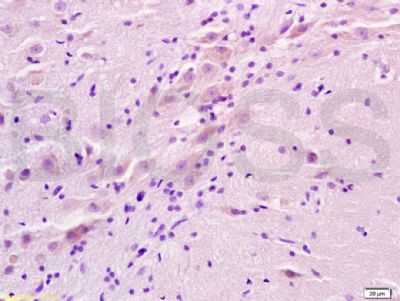
产品细节图片3

相关产品推荐更多 >
万千商家帮你免费找货
0 人在求购买到急需产品
- 详细信息
- 文献和实验
- 技术资料
- 供应商:
上海联迈生物工程有限公司
- 库存:
大量
- 目录编号:
LM-1062R
- 克隆性:
多克隆
- 抗原来源:
Rabbit
- 保质期:
1年
- 抗体英文名:
ADRA2
- 抗体名:
ADRA2肾上腺素能受体2抗体
- 宿主:
Rabbit
- 适应物种:
Human, Mouse, Rat, Pig, Cow, Rabbit,
- 免疫原:
KLH conjugated synthetic peptide derived from human ADRA2:385-450/450 <Cytoplasmic>
- 亚型:
IgG
- 形态:
Lyophilized or Liquid
- 应用范围:
WB=1:500-2000 ELISA=1:500-1000 IHC-P=1:400-800 IHC-F=1:400-800 IF=1:100-500 (石蜡切片需做抗原修复)
- 浓度:
1mg/ml
- 保存条件:
Store at -20 °C
- 规格:
100ul 200ul
| 英文名称 | ADRA2 |
| 中文名称 | ADRA2肾上腺素能受体2抗体 |
| 别 名 | alpha-2A adrenergic receptor; alpha 2a Adrenergic Receptor; ADRA2A; ADRA2; ADRA2R; ADRAR; ALPHA2AAR; ZNF32; RATRG20; RG20; Adrenergic alpha 2A receptor; Alpha 2AAR subtype C10; OTTHUMP00000058849; ADA2A_HUMAN; Alpha-2A adrenergic receptor; Alpha-2 adrenergic receptor subtype C10; Alpha-2A adrenoreceptor; Alpha-2A adrenoceptor; Alpha-2AAR. |
| 规格价格 | 100ul/1380元 购买 200ul/2200元 购买 大包装/询价 |
| 说 明 书 | 100ul 200ul |
| 研究领域 | 神经生物学 生长因子和激素 细胞膜受体 G蛋白偶联受体 G蛋白信号 |
| 抗体来源 | Rabbit |
| 克隆类型 | Polyclonal |
| 交叉反应 | Human, Mouse, Rat, Pig, Cow, Rabbit, |
| 产品应用 | WB=1:500-2000 ELISA=1:500-1000 IHC-P=1:400-800 IHC-F=1:400-800 IF=1:100-500 (石蜡切片需做抗原修复) not yet tested in other applications. optimal dilutions/concentrations should be determined by the end user. |
| 分 子 量 | 50kDa |
| 细胞定位 | 细胞膜 |
| 性 状 | Lyophilized or Liquid |
| 浓 度 | 1mg/ml |
| 免 疫 原 | KLH conjugated synthetic peptide derived from human ADRA2:385-450/450 <Cytoplasmic> |
| 亚 型 | IgG |
| 纯化方法 | affinity purified by Protein A |
| 储 存 液 | 0.01M TBS(pH7.4) with 1% BSA, 0.03% Proclin300 and 50% Glycerol. |
| 保存条件 | Store at -20 °C for one year. Avoid repeated freeze/thaw cycles. The lyophilized antibody is stable at room temperature for at least one month and for greater than a year when kept at -20°C. When reconstituted in sterile pH 7.4 0.01M PBS or diluent of antibody the antibody is stable for at least two weeks at 2-4 °C. |
| PubMed | PubMed |
| 产品介绍 | background: Alpha-2-adrenergic receptors are members of the G protein-coupled receptor superfamily. They include 3 highly homologous subtypes: alpha 2A, alpha 2B, and alpha 2C. These receptors have a critical role in regulating neurotransmitter release from sympathetic nerves and from adrenergic neurons in the central nervous system. Studies in mouse revealed that both the alpha 2A and alpha 2C subtypes were required for normal presynaptic control of transmitter release from sympathetic nerves in the heart and from central noradrenergic neurons; the alpha 2A subtype inhibited transmitter release at high stimulation frequencies, whereas the alpha 2C subtype modulated neurotransmission at lower levels of nerve activity. This gene encodes alpha 2A subtype and it contains no introns in either its coding or untranslated sequences. [provided by RefSeq]. Function: Alpha-2 adrenergic receptors mediate the catecholamine-induced inhibition of adenylate cyclase through the action of G proteins. The rank order of potency for agonists of this receptor is oxymetazoline > clonidine > epinephrine > norepinephrine > phenylephrine > dopamine > p-synephrine > p-tyramine > serotonin = p-octopamine. For antagonists, the rank order is yohimbine > phentolamine = mianserine > chlorpromazine = spiperone = prazosin > propanolol > alprenolol = pindolol. Subcellular Location: Cell membrane. Similarity: Belongs to the G-protein coupled receptor 1 family. Adrenergic receptor subfamily. ADRA2A sub-subfamily. SWISS: P08913 Gene ID: 150 Database links: Entrez Gene: 150 Human Entrez Gene: 11551 Mouse Entrez Gene: 25083 Rat Entrez Gene: 266750 Zebrafish Omim: 104210 Human SwissProt: P08913 Human SwissProt: Q01338 Mouse SwissProt: P22909 Rat SwissProt: Q1L8Y8 Zebrafish SwissProt: Q90WY4 Zebrafish Unigene: 249159 Human Unigene: 235195 Mouse Unigene: 170171 Rat Unigene: 30878 Zebrafish Important Note: This product as supplied is intended for research use only, not for use in human, therapeutic or diagnostic applications. |
| 产品图片 |  Sample: Kidney (Rat) Lysate at 30 ug Brain (Rat) Lysate at 30 ug Primary: Anti- ADRA2 (bs-1062R) at 1/200 dilution Secondary: HRP conjugated Goat-Anti-rabbit IgG (bs-0295G-HRP) at 1/3000 dilution Predicted band size: 50 kD Observed band size: 50 kD  Paraformaldehyde-fixed, paraffin embedded (Rat brain); Antigen retrieval by boiling in sodium citrate buffer (pH6.0) for 15min; Block endogenous peroxidase by 3% hydrogen peroxide for 20 minutes; Blocking buffer (normal goat serum) at 37°C for 30min; Antibody incubation with (ADRA2) Polyclonal Antibody, Unconjugated (bs-1062R) at 1:500 overnight at 4°C, followed by a conjugated secondary (sp-0023) for 20 minutes and DAB staining. Tissue/cell: rat brain tissue; 4% Paraformaldehyde-fixed and paraffin-embedded; Antigen retrieval: citrate buffer ( 0.01M, pH 6.0 ), Boiling bathing for 15min; Block endogenous peroxidase by 3% Hydrogen peroxide for 30min; Blocking buffer (normal goat serum,C-0005) at 37℃ for 20 min; Incubation: Anti-ADRA2 Polyclonal Antibody, Unconjugated(bs-1062R) 1:200, overnight at 4°C, followed by conjugation to the secondary antibody(SP-0023) and DAB(C-0010) staining |
风险提示:丁香通仅作为第三方平台,为商家信息发布提供平台空间。用户咨询产品时请注意保护个人信息及财产安全,合理判断,谨慎选购商品,商家和用户对交易行为负责。对于医疗器械类产品,请先查证核实企业经营资质和医疗器械产品注册证情况。
 文献和实验
文献和实验从毒品到抗抑郁药物,中国研究团队 Nature 揭示「K 粉
:Nature该文章解析了 NMDA 受体结合快速抗抑郁药氯胺酮的冷冻电镜结构,为靶向 NMDA 受体设计新型抗抑郁药的研发提供了重要基础。人 GluN1-GluN2A 和 GluN1-GluN2B NMDA 受体与 S-氯胺酮结合的冷冻电镜结构抑郁症是世界第四大疾病,但我们国家对抑郁症的诊断和识别仍然不足,抑郁症在近年来呈现低龄化趋势,同时对于抑郁症的治疗也没有特效药物。目前主要用于临床的一些药物包括 5-羟色胺再摄取抑制剂、5-羟色胺和去甲肾上腺素再摄取抑制剂等。氯胺酮由于它快速起效的特点,可以在短时
,从而将目的基因靶向性地导入肿瘤细胞。Khare等将抗人癌胚抗原(CEA)单链抗体编码基因与env基因重组,使反转录病毒将“自杀基因”――一氧化氮合成酶(NOS)靶向导人CEA阳性的肿瘤细胞,并通过过度合成NOS杀死肿瘤细胞。 靶向转移目的基因策略的工作原理 另一个例子是腺病毒。腺病毒载体在感染靶细胞时,首先依靠通过病毒衣壳(capsid)上的纤维蛋白(nber)头部的knob结构域识别并结合靶细胞表面的“柯萨奇病毒和腺病毒受体”(CAR),然后通过衣壳的五邻体
〔1〕受体,亦称感受器。对细胞而言,一般被定义为:能识别外来物质,靠与其特异的结合引起细胞反应的结构体。本来是为了阐明生物活性物质与细胞间的关系,或其对细胞作用机理而引进的一个必要的概念,目前还多在这种意义上使用,而从物质上逐渐加以阐明。在概念意义上讲,过去一直被沿用的受体概念有α受体和β受体,这是为了说明去甲肾上腺素有两种不同的作用而引进的。即被作用细胞有各种受体,由于在不同的受体部位作用,当然就会表现出不同的效应。这种受体在物质上还未被弄清楚。已知肽激素受体位于细胞膜上。当不同
 技术资料
技术资料暂无技术资料 索取技术资料









